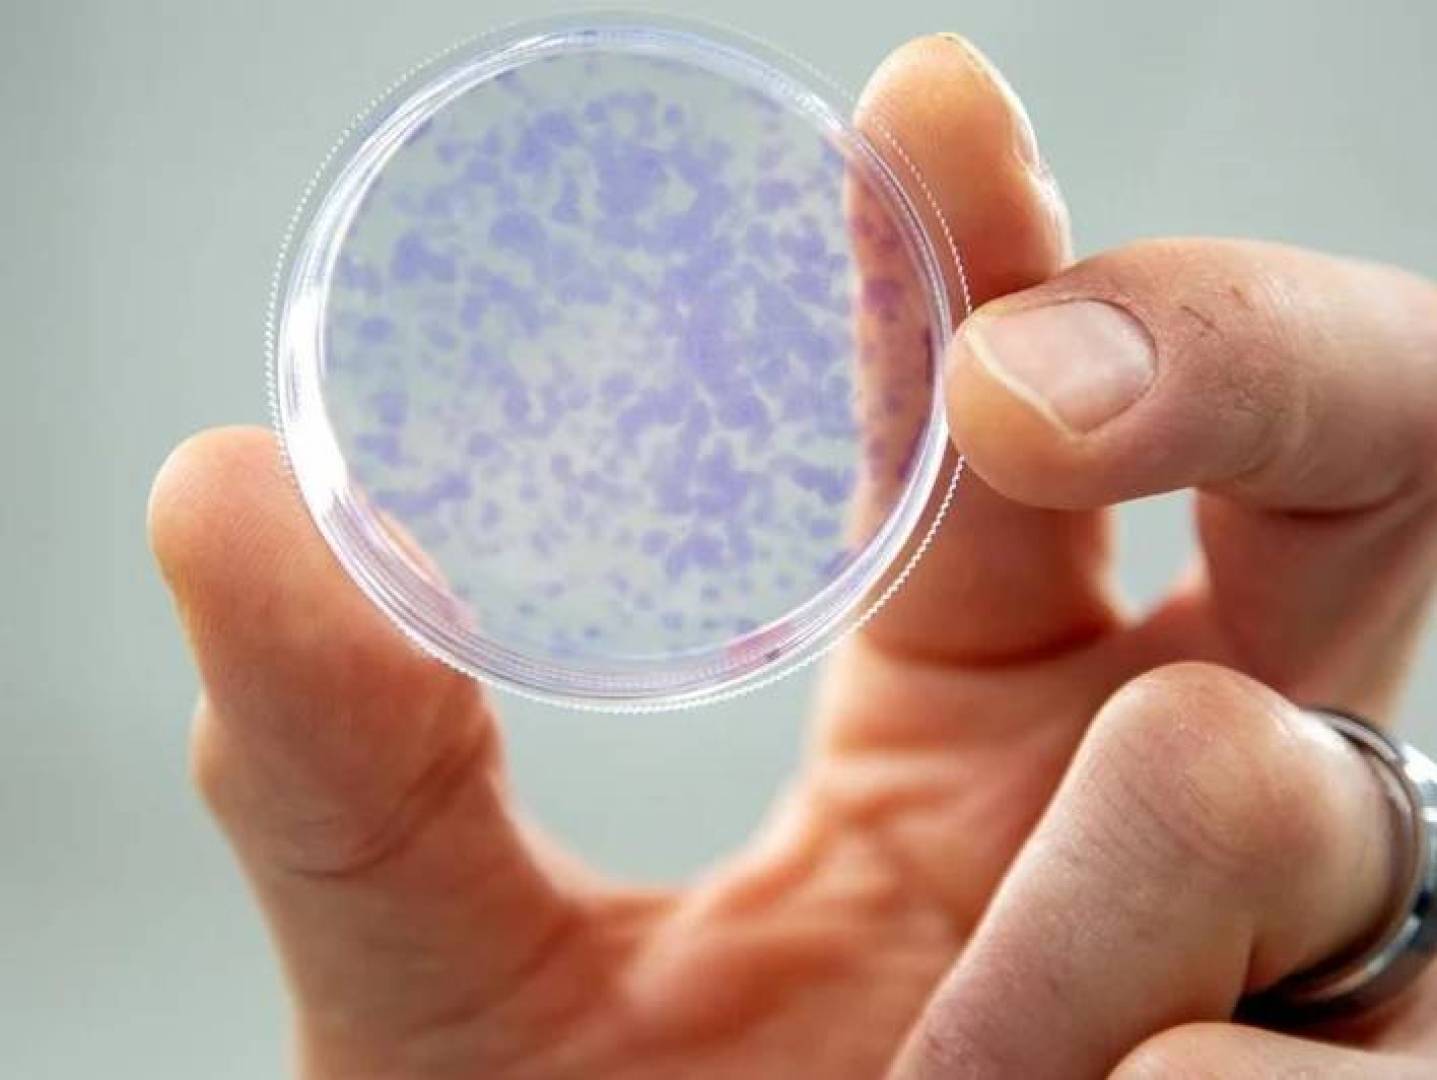
العلماء يكتشفون وسيلة لتشخيص خطر سرطان الرئة من أظافر القدم

أعلن باحثون كنديون من جامعة كالغاري أنهم تمكنوا من تحديد خطر الإصابة بسرطان الرئة من خلال تحليل أظافر القدم ، بعد أن اكتشفوا احتواءها على آثار من غاز الرادون المشع — وهو ثاني أكبر سبب للإصابة بسرطان الرئة بعد التدخين.
هذا الاكتشاف المذهل، الذي نُشر في مجلة Environment International، قد يفتح الباب أمام وسيلة غير جراحية للكشف المبكر عن الأشخاص المعرضين لخطر المرض قبل ظهور أي أعراض.
ما هو غاز الرادون ولماذا يشكّل خطراً خفياً؟
غاز الرادون هو غاز مشع عديم اللون والرائحة، يتكوّن طبيعياً من تحلّل اليورانيوم في التربة والصخور.
تكمن خطورته في أنه يتسلل إلى المنازل ويتركّز في الأماكن المغلقة، خصوصاً في الأقبية والطوابق الأرضية ذات التهوية الضعيفة.
عند استنشاقه، يتحول داخل الرئتين إلى رصاص مشع (Pb-210)، يلتصق بالأنسجة ويُسبب تلفاً تدريجياً للخلايا قد يؤدي إلى تطور سرطان الرئة بمرور الوقت.
وفقاً للعلماء، يُصاب آلاف الأشخاص سنوياً بسرطان الرئة نتيجة التعرض للرادون دون علمهم، لأنه غاز لا يمكن رؤيته أو شمّه.
تحليل الأظافر يكشف تراكم الرادون في الجسم
اعتمد الباحثون في جامعة كالغاري على تحليل عينات من أظافر القدم لـ 55 شخصاً، ووجدوا أن معظم المشاركين احتووا على نظائر الرصاص المشع (Pb-210) — وهي ناتجة مباشرة عن التعرض لغاز الرادون.
وكانت النتائج أربع مرات أعلى لدى الأشخاص الذين عاشوا في منازل تحتوي على مستويات مرتفعة من الرادون مقارنةً بغيرهم.
الأمر اللافت أن آثار الرصاص المشع بقيت في الأنسجة حتى بعد مرور ست سنوات على انخفاض تركيز الغاز في البيئة المحيطة، ما يشير إلى أن أظافر القدم يمكن أن تحفظ “سجلاً إشعاعياً” طويلاً للتعرض.
أهمية هذا الاكتشاف
يُعتبر هذا الاكتشاف إنجازاً واعداً في الطب الوقائي، إذ يتيح إمكانية تحديد الأشخاص المعرضين لخطر الإصابة بسرطان الرئة قبل ظهور الأعراض السريرية.
ويعمل العلماء حالياً على دراسة موسعة تشمل أكثر من 10,000 شخص في كندا، حيث يتم قياس مستويات الرادون في منازلهم ومقارنتها بالتركيب الكيميائي لأظافرهم.
الهدف من هذه الأبحاث هو تطوير اختبار بسيط ودقيق يمكن تطبيقه مستقبلاً في الفحوصات الطبية الروتينية، مما قد يساهم في خفض معدلات الوفيات الناتجة عن سرطان الرئة.
أمل جديد في مواجهة السرطان الصامت
يرى الخبراء أن فهم العلاقة بين الرادون وأظافر القدم يمثل ثورة في طرق الكشف المبكر عن السرطان، إذ يمكن أن يساعد على حماية حياة الآلاف حول العالم من هذا المرض الخفي الذي غالباً لا يُكتشف إلا في مراحله المتقدمة.